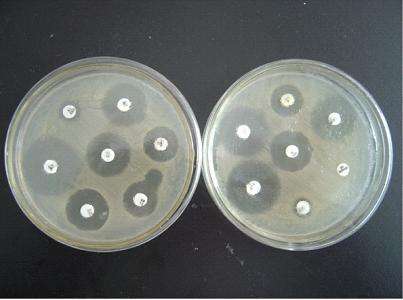
人得了猫癣怎么防止它越长越多 (猫病猫藓)

凡是伺候猫主子的铲屎官,多多少少都能听说过“猫藓”的大名。
猫癣,也就是皮肤癣菌病,是指由癣菌(主要为犬小孢子菌)引起的真菌性皮肤问题。

(这些就是罪魁祸首)
其实从原理上来讲,这个猫藓和人的脚气,原理是一模一样的。
但也和人的香港脚一样,猫藓想要治好,还真不是那么容易。

首先,猫藓和大部分病一样,虽然病原体是一种因素,但还有另一个因素:猫咪的抵抗力。
绝大部分猫咪得猫藓的原因有两种:一是突然接触大量真菌,比如被患有猫藓的猫咪传染、睡眠于滋养真菌的潮湿猫窝内;
第二种则是皮肤抵抗力过低,被真菌寄养,比如小猫老猫更易感染猫藓、伙食和天气突然改变也容易让猫咪易感猫藓。

而大部分的家养猫咪之所以得了猫藓,主要还因为第二种原因。
所以有时候你发现自己家猫咪开始在一个区域开始掉毛,但是还没有秃的时候,加强猫咪的营养,尽量不要改变环境,是有可能好转的哟。
如果你们家猫咪有一块地方变“秃”了,那小艾推荐还是去医院做个检查比较好。

检查主要有这三板斧:皮肤刮片、伍氏灯和真菌培养。
皮肤刮片,顾名思义,就是刮下皮屑镜检,判断到底是真菌、细菌、还是螨虫导致你们家猫咪脱毛。

而伍氏灯就比较神奇了,其原理类似于验钞机。把你们家猫咪放到灯下一照,如果“熠熠生辉”,那“恭喜”你,是真菌感染没跑了。

而真菌培养就比较好理解了,将刮下的真菌进行培养和耐药性检测,就可以判断具体感染你们家猫咪的是哪种真菌。不过培养时间会比较长,一般在一周左右。
如果确诊了,那医生一般会通过以下方法进行治疗:
首先,如果不是很严重,比如只有局部很小的掉毛。

那么治疗一般以外*剂喷**为主,常见的药物是皮特芬。

但皮特芬有一定的毒性,所以喷完后一定要带伊丽莎白项圈,防止猫咪舔舐。
如果是比较严重的猫藓,比如全身各处散在

或者在某一处有大片存在。
那么主人就需要做好持久战的准备。
除了外喷药物以外,还要口服抗真菌药物,比如伊曲康唑等,同时要对猫咪进行药浴,大概一周两次。

大范围猫藓是比较难痊愈的,主人要做好花1-2个月的时间来治疗的准备。
在发生猫藓的时候,不要轻易剃毛。虽然剃毛能有效加强药浴效果,不过盲目的剃毛也会导致真菌的传播,请在医生的指导下进行操作。
猫藓同时也是高传染性的皮肤病,不但传猫,而且还传染人!所以保护措施和隔离措施一定要做好。
